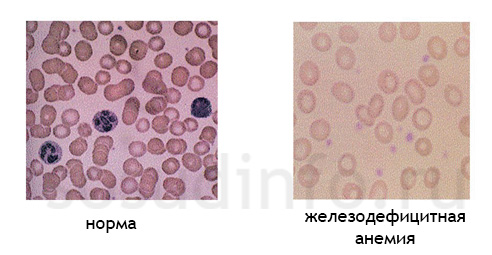
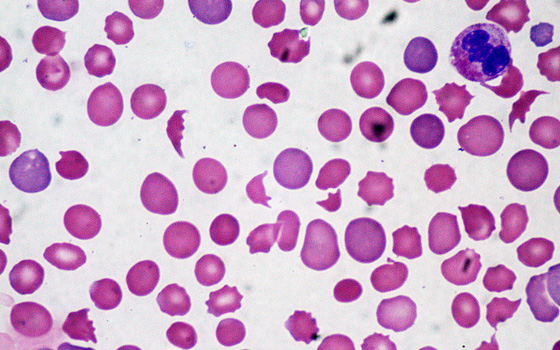

- Причини і загальні ознаки анемій
- Відео: що таке анемія і які частини тіла від неї страждають?
- постгеморрагические анемії
- Анемії, що розвиваються на тлі порушень освіти крові
- Ліки при залізодефіцитної анемії
- Дієта при анемії
- Відео: залізодефіцитна анемія - причини і лікування
- анемія Фанконі
- мегалобластні анемії
- В-12-дефіцитна анемія
- фолієводефіцитна анемія
- гемолітічні анемії
- Cерповідно-клітинна анемія
- Аутоімунна гемолітична анемія
- Відео: анемія в програмі "Жити здорово!"
Людська кров за своїм складом є сумішшю плазми (рідкої основи) і елементарних твердих частинок, представлених тромбоцитами, лейкоцитами і еритроцитами. У свою чергу тромбоцити відповідають за згортання, лейкоцити підтримують в нормі імунітет, а еритроцити є переносниками кисню.
Якщо з яких-небудь причин утримання в крові еритроцитів ( гемоглобіну ) Знижується, то така патологія називається недокрів'ям або анемією. Загальні симптоми захворювання проявляються у вигляді блідості, слабкості, запаморочення та ін. В результаті анемії в тканинах нашого організму починається гостра нестача кисню.
Анемія найчастіше виявляється у жінок, ніж у чоловіків. Ця патологія може виникнути на тлі будь-яких захворювань, а також розвинутися як самостійна хвороба.
Причини і загальні ознаки анемій
Спровокувати анемію може досить багато факторів. Одними з найбільш частих причин анемії по праву вважаються нестача фолієвої кислоти, заліза або вітаміну В12. Також анемія розвивається через рясні кровотечі під час менструації або на тлі деяких онкологічних хвороб. Часто недокрів'я проявляється через недостатність речовин, які відповідають за вироблення гемоглобіну, а також збої в процесі утворення еритроцитів. Передаються у спадок захворювання і вплив отруйних речовин теж можуть стати причиною розвитку недокрів'я.

Найчастіше у страждаючих анемією відзначаються такі симптоми:
- Жовтувата, лущиться, холодна на дотик і бліда шкіра.
- Слабкість, швидка стомлюваність, сонливість і запаморочення, у важких випадках супроводжуються непритомністю.
- Знижений артеріальний тиск.
- Жовтуватий відтінок очних білків.
- Задишка.
- Ослаблений м'язовий тонус.
- Прискорене биття серця.
- Збільшення розмірів селезінки.
- Змінений колір стільця.
- Липкий, холодний піт.
- Блювота, нудота.
- Поколювання в ногах і руках.
- Починають випадати волосся і ламатися нігті.
- Часті головні болі.

Відео: що таке анемія і які частини тіла від неї страждають?
Класифікація
В цілому класифікація анемії грунтується на трьох групах:
- Постгеморрагические анемії, тобто недокрів'я, викликане сильною крововтратою .
- Анемія, що утворилася на тлі порушень в процесі утворення крові, а також патологій в синтезі РНК і ДНК - мегалобластна, залізодефіцитна, фолиеводефицитная, В-12-дефіцитна, гіпопластична, апластична, анемія Фанконі та ін. Види.
- Гемолітичні анемії, тобто недокрів'я, що виникає унаслідок підвищеного еритроцитної руйнування (аутоімунна гемолітична анемія, серповидноклітинна анемія та ін.).
Крім цього, анемія поділяється і на кілька ступенів тяжкості, які залежать від вмісту гемоглобіну. це:
- Важка ступінь - коли гемоглобіну в складі крові менше, ніж 70 гл.
- Середня - 70-90 г / л.
- Легка - більше 90 г / л (анемія 1 ступеня).
постгеморрагические анемії
Дані види анемій можуть бути хронічної або гострої форми. Хронічні як правило, є наслідком неодноразових втрат крові, наприклад, при пораненнях і травмах, рясних менструаціях, виразці шлунка, геморої або ракових захворюваннях і ін. Гостра форма постгеморагічної анемії розвивається через одноразовою, але значної крововтрати.
При цьому клініка гострого постгеморагічного недокрів'я представлена значним погіршенням загального стану пацієнта, пов'язаним з гіпоксією (нестачею кисню) : Прискореним серцебиттям, миготінням «мошок», слабкістю, задишкою, шумом у вухах, запамороченням і т.д. Колір шкіри стає значно блідіше, іноді з жовтуватим відтінком. Загальна температура тіла хворого знижена, очні зіниці розширені.
Цікавим є той факт, що аналіз крові, проведений протягом 2-3 годин після крововтрати (при гострій формі постгеморагічного недокрів'я) показує нормальний вміст еритроцитів і гемоглобіну. Їх показники починають знижуватися пізніше. Варто зазначити, що кров при цьому згортається значно швидше.
Найдієвішим способом лікування анемії постгеморрагической форми вважається переливання крові . Після чого лікар, як правило, призначає хворому прийом антианемічних засобів, збагачене білками харчування.
Якщо ж форма хронічна, то, як правило, особливих змін в стані пацієнт не помічає. Зазвичай спостерігається деяка блідість, запаморочення при різкому вставанні і слабкість. У початкових стадіях нормальний склад крові забезпечується кістковим мозком. Згодом він з цією функцією вже не справляється і розвивається гіпохромна анемія. Це недокрів'я, при якому колірний показник крові знаходиться на низькому рівні, що говорить про низький вміст гемоглобіну в еритроцитах. У пацієнта при цьому починають ламатися нігті і випадати волосся.

При хронічній формі постгеморагічного недокрів'я залозу стає важко засвоюватися в організмі, що призводить до суттєвих порушень, пов'язаних з утворенням гемоглобіну. Максимальна ефективність лікування досягається шляхом нейтралізації джерела втрати крові.
На додаток призначається прийом залізовмісних препаратів. Найбільш популярні і дієві в цьому випадку ліки від анемії: ферроплекс, феррум лек, конферон, феррокаль, феромід тощо. Лікування залізовмісними препаратами протікає досить довгий час. Лікарі радять переглянути раціон - він повинен грунтуватися на продуктах, збагачених тваринним білком (м'ясо, печінка) і містять багато заліза (гречка, яблука, гранат).
Анемії, що розвиваються на тлі порушень освіти крові
залізодефіцитні анемії
Як правило, залізодефіцитна анемія (ЗДА) розвивається через брак в організмі такого елемента як залізо. Цьому можуть сприяти різні порушення, пов'язані з засвоєнням заліза, або ж вживана їжа бідна на цей елемент (наприклад, у тих, хто сидить на жорсткій і тривалої дієти). Також ЗДА часто зустрічається у донорів і людей, які страждають гормональними порушеннями.
Крім перерахованого вище, ЗДА може виникнути через тривалі і рясні менструальних або ракових кровотеч. Досить часто ця анемія діагностується у вагітних, оскільки їхні потреби в цьому елементі на час вагітності значно зростають. І взагалі, ЗДА найчастіше зустрічаються у дітей і жінок.
Залізодефіцитна анемія під мікроскопом
Симптомів залізодефіцитної анемії досить багато і вони часто схожі з симптоматикою інших анемій:
- По-перше, шкіра. Вона стає тьмяною, блідою, лущиться і сухої (зазвичай на руках і обличчі).
- По-друге, нігті. Вони стають ламкими, тьмяними, м'якими і починають розшаровуватися.
- По-третє, волосся. У людей з ЗДА вони стають ламкими, січеться, починають інтенсивно випадати і повільно зростати.
- По-четверте, зуби. Одним з характерних ознак залізодефіцитної анемії є розфарбовування зубів і карієс. Емаль на зубах стає шорсткою, а самі зуби втрачають колишній блиск.
- Часто ознакою анемії виступає захворювання, наприклад, атрофічний гастрит, функціональні порушення кишечника, сечостатевої сфери тощо.
- Хворі ЗДА страждають смаковим і нюховим збоченням. Це проявляється в бажанні з'їсти глину, крейду, пісок. Часто таким пацієнтам несподівано починає подобатися запах лаку, фарби, ацетону, бензину, вихлопних газів і ін.
- Залізодефіцитна анемія відбивається і на загальному стані. Її супроводжують часті болі в області голови, прискорене серцебиття, слабкість, миготіння «мошок», запаморочення, сонливість.
Аналіз крові при ЗДА показує серйозне падіння гемоглобіну. Рівень еритроцитів знижений також, але в меншій мірі, так як анемія носить гіпохромний характер (колірний показник має тенденцію до зниження). У кров'яної же сироватці вміст заліза значно падає. З периферичної крові повністю зникають сідероціти.
Ліки при залізодефіцитної анемії
Лікування грунтується на прийомі залізовмісних ліків як таблетованих, так і у вигляді ін'єкцій. Найчастіше лікар виписує препарати заліза зі списку, представленого нижче:
- Феррум-лек;
- феррокаль;
- ферковен;
- Феррамід;
- ферроплекс;
- фербітол;
- гемостимулин;
- Імферон;
- Конферон тощо.
Дієта при анемії

Крім лікарських препаратів лікарі радять дотримуватися певної дієти, пов'язаної з обмеженням борошняних, молочних і жирних продуктів. Корисні такі продукти як гречка, картопля, часник, зелень, печінка, м'ясо, шипшина, смородина та ін.
Найчастіше розвивається дана анемія при вагітності. Хворим з ЗДА корисний як лісовий, так і гірське повітря, фізкультура. Бажано вживати мінеральну воду з железноводских, Марціальні і ужгородських джерел. Не варто забувати і про профілактику в осінньо-весняні періоди, коли організм особливо ослаблений. У ці періоди буде корисна дієта при анемії, багата залізовмісними продуктами харчування (див. Вище і на малюнку справа).
Відео: залізодефіцитна анемія - причини і лікування
Апластичні і гипопластические анемії
Ці анемії є комплекс патологій, що характеризуються функціональною недостатністю кісткового мозку. Апластична анемія відрізняється від гіпопластичного більш пригніченим кроветворением.
Найчастіше виникнення гіпопластична анемія сприяє радіація, певні інфекції, негативний вплив хімічних або лікарських препаратів, або спадковість. Всі можливі форми гіпо- та апластичні анемій мають поступовий характер розвитку.
Виявляються ці анемії підвищенням температури, ангіною, сепсисом, зайвою вагою, блідістю, носовими і ясен кровотечами , Дрібноточковими капілярними крововиливами на слизових і шкірі, печіння в роті. Часто захворювання супроводжується ускладненнями інфекційної природи, наприклад, абсцес після уколу, пневмонія та ін.). Часто страждає і печінка - вона, як правило, стає більше.
Железообмен в організмі порушується, при цьому кількість заліза в крові підвищений. Лейкоцитів у складі крові стає набагато менше, як і гемоглобіну, а от молоді форми еритроцитів зовсім відсутні. У калових масах і сечі часто присутні кров'янисті домішки.

Формування клітин крові з кісткового мозку. При апластичної і гипопластической анеміях спостерігаються порушення при виробленні лейкоцитів
В тяжкого ступеня апластична анемія (як і гіпопластична) чревата летальним результатом. Лікування дасть хороші результати тільки в разі своєчасності. Воно проводиться тільки в стаціонарі і має на увазі підвищений гігієнічний догляд за ротовою порожниною і шкірних покривів. При цьому здійснюється кількаразове переливання крові, антибіотикотерапія, прийом вітамінів і гормонів, а також бажано повноцінне харчування при анемії. Іноді лікарі вдаються до пересадки (переливання) кісткового мозку (це можливо при наявності донора, сумісного за HLA-системі, яка передбачає спеціальний підбір).
анемія Фанконі
Це досить рідко зустрічається різновид вроджених анемій, пов'язана з хромосомними аномаліями, дефектами в стовбурових клітинах. Зустрічається переважно у хлопчиків. У новонароджених ця патологія, як правило, не спостерігається. Для неї характерні симптоматичні прояви в 4-10-річному віці у вигляді кровотеч і крововиливів.
В кістковому мозку спостерігається збільшення жирових тканин, при цьому клітинної знижена, а кровотворення має пригноблений характер. Дослідження показують, що у дітей з анемією Фанконі еритроцити живуть ≈ в 3 рази менше норми.
Для зовнішності хворого з цієї анемією характерна ненормальна пігментація, маленький зріст, недорозвиненість черепа або скелета, клишоногість. Нерідко ці симптоми доповнюються розумовою відсталістю, косоокістю, глухотою, недорозвиненістю статевих органів, нирок, пороком серця .
Аналізи крові показують зміни, схожі з апластичну анемію, тільки виражені вони набагато менше. Аналіз сечі у більшості пацієнтів показує на високий вміст в ній амінокислот.

Анемія Фанконі - окремий випадок апластичної анемії з порушенням утворення еритроцитів в кістковому мозку
Хворі на анемію Фанконі, згідно з дослідженнями, мають високу схильність до гострого лейкозу.
За своєю суттю, анемія Фанконі є важкою формою апластичної анемії, описаної вище. Лікування полягає у видаленні селезінки, із застосуванням після цього антилимфоцитарного глобуліну. Також застосовуються імунодепресанти, андрогени. Але найефективнішим лікуванням зарекомендувала себе пересадка кісткового мозку (донори - сестра або брат хворого або чужі люди, що збігаються по HLA-фенотипу).
Дана патологія ще недостатньо вивчена. Хоча, незважаючи на вроджену природу, ця анемія у немовлят не проявляється. Якщо ж захворювання діагностовано пізно, то такі хворі не проживають більше 5 років. Смерть настає через крововиливів в шлунок або мозок.
мегалобластні анемії
Ці анемії є як спадковими, так і набутими. Для них характерна наявність мегалобластів в кістковому мозку. Це такі ядерні клітини, які є попередниками еритроцитів і містять неконденсоване хроматин (в такій клітці молоде ядро, але навколишня його цитоплазма вже стара).
І В-12-дефіцитна, і фолиеводефицитная анемії відносяться до підвиду мегалобластноїанемії. Іноді навіть діагностується змішана В-12-фолиеводефицитная анемія, але зустрічається вона досить рідко.
В-12-дефіцитна анемія
В-12-дефіцитне недокрів'я розвивається через брак вітаміну В-12. Цей мікроелемент необхідний для правильного функціонування нервової системи, а також він потрібен кістковому мозку для освіти і зростання в ньому еритроцитів. В-12 бере участь безпосередньо в синтезі РНК і ДНК, тому-то і порушується процес утворення розвитку еритроцитів при його нестачі.
для В 12-дефіцитної анемії відмітною ознакою є деяка хиткість в ході, оніміння та відчуття поколювання в пальцях . Також хвороба супроводжується серцевими болями, набряками кінцівок, слабкістю, зниженою працездатністю, блідою желтушностью і одуловатостью особи, шумом у вухах, печіння і сверблячкою на мові.
Зазвичай брак В-12 настає через порушення його всмоктування. Цьому більше схильні люди, які мають атрофію шлункових слизових, хронічний ентерит, глютенову хвороба. Дефіцит В-12 може стати наслідком панкреатиту. Часто він зустрічається у вегетаріанців, а також людей похилого віку.
Таке недокрів'я ще називають пернициозной анемією. Розвивається захворювання дуже повільно, переходячи, як правило, в хронічну рецидивуючу форму.
Лікування здійснюється за допомогою парентерального застосування вітаміну В-12 (роблять щоденні внутрішньом'язові ін'єкції). Також показаний раціон, збагачений В-12-містять продуктами: печінку, яйця, молочні продукти, м'ясо, сир, нирки.
фолієводефіцитна анемія
Фолієводефіцитна недокрів'я являє собою гостру нестачу в організмі фолієвої кислоти. Вона теж (як і В-12) бере активну участь в утворенні еритроцитів. Фолієва кислота доставляється в наш організм через продукти харчування (м'ясо, шпинат і ін.), Але при термічній обробці цих продуктів вона втрачає свою активність.
Фолиеводефицитной анемії зазвичай схильні люди, які страждають глютеновой хворобою, наркоманією та алкоголізмом. Спостерігається вона і в осіб, які довго приймають ліки від судом (фенобарбіта, дифенін та ін.). Також спровокувати цю анемію можуть поліпи або рак шлунка, кишкові патології і паразити, гепатити та цироз печінки.

Така анемія найчастіше проявляється у дітей, яких годували козячим або порошковим молоком, і у вагітних жінок. При цьому хвороба супроводжується запамороченням і слабкістю, задишкою і стомлюваністю. Шкіра стає сухуватою і набуває блідого жовтувато-лимонний відтінок. Хворого може часто морозить і лихоманити.
Зміни в крові ідентичні В-12-дефіцитної анемії. Як правило, гемоглобін залишається в нормі, а іноді навіть підвищений. У складі крові присутні макроціти - це еритроцити, мають збільшений розмір. Для фолиеводефицитной анемії взагалі характерно знижений кількість всіх кров'яних клітин при збільшенні їх розміру. Це гіперхромні анемія з досить високим показником кольору. Біохімія крові показує, що вільний білірубін трохи підвищений.
Фолієводефіцитна недокрів'я лікують за допомогою лікарських препаратів фолієвої кислоти в таблетованій формі. Крім цього слід підкоригувати і харчування пацієнта (переважні листові овочі, печінка, більше фруктів).
Окремо слід відзначити, що В-12- і фолиеводефицитная анемія є різновидами макроцитарной анемії - це патологія, що характеризується збільшенням розмірів еритроцитів через гостру нестачу В-12 або фолієвої кислоти.
гемолітічні анемії
Всі різновиди ціх анемій обумовлені надмірнім руйнування еритроцитів. У нормі длительность життя еритроцитів ставити ≈120 діб. Коли ж у людини з'являються антитіла проти його ж еритроцитів, то починається різке еритроцитарної руйнування, тобто життя еритроцитів стає значно коротше (≈13суток). Гемоглобін в крові починає розпадатися, через що у хворого розвивається жовтяниця на тлі гемолітичної анемії.
Лабораторним симптомом такої анемії є підвищений білірубін, присутність в сечі гемоглобіну та ін.
Значне місце серед таких анемій займають спадкові різновиди. Вони є наслідками безлічі дефектів в утворенні еритроцитів на генетичному рівні. Придбані різновиди гемолітичних анемій розвиваються на тлі певних факторів, що на еритроцити руйнівну дію (вплив механічного характеру, різні отрути, антитіла і т. Д.).
Cерповідно-клітинна анемія
Однією з поширених спадкових гемолітичних анемій є серповидно-клітинна. Це захворювання має на увазі присутність патологічного гемоглобіну в еритроцитах. Ця патологія частіше вражає афроамериканців, але зустрічається і у світлошкірих людей.
Наявність в крові серповидних еритроцитів, характерне для цієї патології, її носію зазвичай нічим не загрожує. Але якщо і мати, і батько мають в крові цей патологічний гемоглобін, то їхні діти ризикують народитися з важкою формою серповидно-клітинної недокрів'я, саме тому така анемія небезпечна.
фото: кров при гемолітичної анемії. Еритроцити - неправильної форми
Супроводжується цей різновид анемії ревматичними болями, слабкістю, болями в животі і голові, сонливістю, припухлості гомілок, кистей і стоп. Лікарський огляд виявляє блідість слизових та шкіри, збільшену селезінку і печінку. Для мають цю патологію людей характерно худе статура, високий зріст і викривлений хребет.
Аналіз крові показує помірну, або важку ступінь анемії, причому показник кольору буде в нормі.
Дана патологія - дуже тяжке захворювання. Основна маса пацієнтів помирає, як правило, не доживши до десятирічного віку, з причини якої-небудь інфекції (частіше туберкульозу) або внутрішнього крововиливу.
Лікування цього недокрів'я є симптоматичним. Хоч воно і вважається хронічною анемією, діти досить легко переносять низький вміст еритроцитів і гемоглобіну. Саме тому їм досить-таки рідко проводять переливання крові (частіше у випадках апластичної або гемолітичного кризу). Слід уникати всіляких інфекцій, особливо дітям.
Аутоімунна гемолітична анемія
Серед придбаних різновидів частіше зустрічається аутоімунна гемолітична анемія. Вона має на увазі вплив утворилися в організмі хворого антитіл. Такий різновид зустрічається, як правило, при хронічних цирозах і гепатитах, ревматоїдних артритах, гострому лейкозі, або хронічному лімфолейкозі.
Буває хронічна, а також гостра форма аутоімунною гемолітичної анемії. Хронічна форма протікає практично без характерних симптомів. При гострій формі хворий страждає жовтяницею, задишкою, слабкістю, лихоманкою, частим серцебиттям. Калові маси через надмірний вміст стеркобилина мають темно-коричневий відтінок.
Хоча і рідко, але можна зустріти аутоіммунну анемію з повними холодовим антитілами, яка властива людям похилого віку. Холод в подібних випадках виступає в качестве6 провокуючого фактора, що призводить до набряку і посиніння пальців рук, обличчя, стоп. Часто аутоиммунная анемія такого типу супроводжується синдромом Рейно, який, на жаль, може закінчитися гангреною пальців. Крім цього, у хворих з холодової аутоімунної анемією неможливо визначити групу крові традиційними методами.
Лікування здійснюється за допомогою глюкокортикоїдних гормонів. Важливу роль в лікуванні відіграє його тривалість і правильне дозування препаратів. Також в лікуванні лікарі використовують цитостатичні препарати, проводять плазмаферез, а при необхідності - спленектомію.
Відео: анемія в програмі "Жити здорово!"
Слід пам'ятати, що багато різновидів анемій при неправильному їх лікуванні можуть мати найважчі наслідки для організму, аж до летального результату. Тому не треба займатися самолікуванням. Діагноз повинен поставити кваліфікований лікар, так само як і призначити ефективне і правильне лікування!
Відео: що таке анемія і які частини тіла від неї страждають?